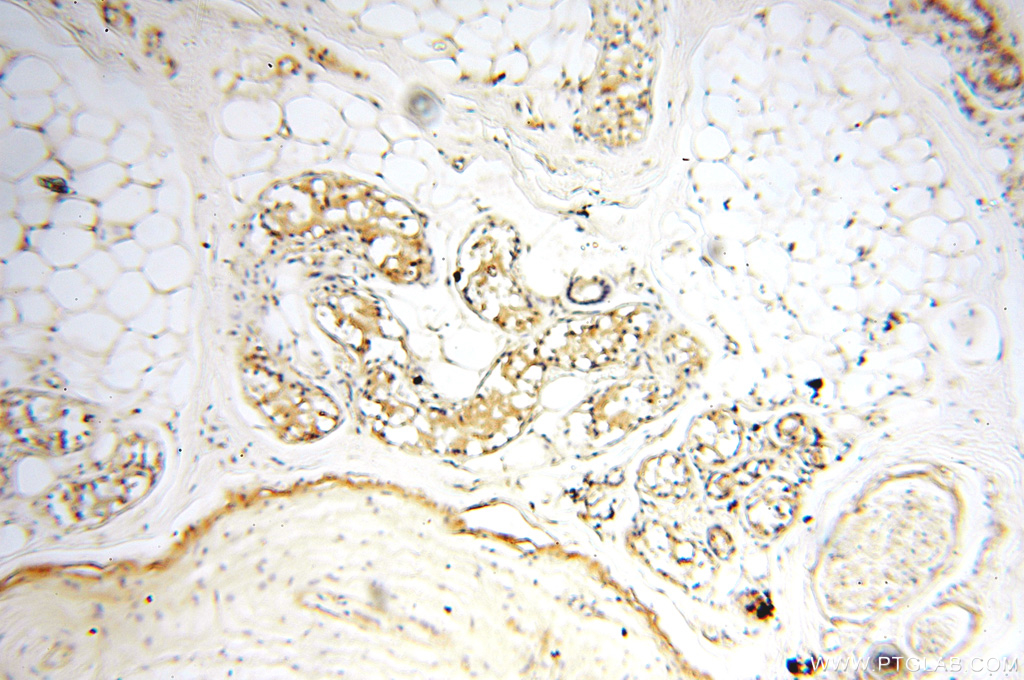

验证数据展示
经过测试的应用
| Positive WB detected in | mouse brain tissue, rat brain tissue |
| Positive IHC detected in | human placenta tissue, human heart tissue, human kidney tissue, human lung tissue, human ovary tissue, human skin tissue, human spleen tissue, human testis tissue Note: suggested antigen retrieval with TE buffer pH 9.0; (*) Alternatively, antigen retrieval may be performed with citrate buffer pH 6.0 |
| Positive IF-P detected in | mouse brain tissue |
推荐稀释比
| 应用 | 推荐稀释比 |
|---|---|
| Western Blot (WB) | WB : 1:1000-1:4000 |
| Immunohistochemistry (IHC) | IHC : 1:50-1:500 |
| Immunofluorescence (IF)-P | IF-P : 1:50-1:500 |
| It is recommended that this reagent should be titrated in each testing system to obtain optimal results. | |
| Sample-dependent, Check data in validation data gallery. | |
产品信息
18290-1-AP targets MEF2C in WB, IHC, IF-P, ChIP, ELISA applications and shows reactivity with human, mouse, rat samples.
| 经测试应用 | WB, IHC, IF-P, ELISA Application Description |
| 文献引用应用 | WB, IHC, IF, ChIP |
| 经测试反应性 | human, mouse, rat |
| 文献引用反应性 | human, mouse, chicken |
| 免疫原 |
Peptide 种属同源性预测 |
| 宿主/亚型 | Rabbit / IgG |
| 抗体类别 | Polyclonal |
| 产品类型 | Antibody |
| 全称 | myocyte enhancer factor 2C |
| 别名 | myocyte enhancer factor 2C, Myocyte-specific enhancer factor 2C |
| 计算分子量 | 51 kDa |
| 观测分子量 | 45-70 kDa |
| GenBank蛋白编号 | NM_002397 |
| 基因名称 | MEF2C |
| Gene ID (NCBI) | 4208 |
| RRID | AB_2142849 |
| 偶联类型 | Unconjugated |
| 形式 | Liquid |
| 纯化方式 | Antigen affinity purification |
| UNIPROT ID | Q06413 |
| 储存缓冲液 | PBS with 0.02% sodium azide and 50% glycerol, pH 7.3. |
| 储存条件 | Store at -20°C. Stable for one year after shipment. Aliquoting is unnecessary for -20oC storage. |
背景介绍
MEF2C belongs to the MEF2 family. It is a transcription activator which binds specifically to the MEF2 element present in the regulatory regions of many muscle-specific genes. MEF2C controls cardiac morphogenesis and myogenesis, and is also involved in vascular development[PMID: 20221419]. It plays an essential role in hippocampal-dependent learning and memory by suppressing the number of excitatory synapses and thus regulating basal and evoked synaptic transmission[PMID:18599438]. It is crucial for normal neuronal development, distribution, and electrical activity in the neocortex and is necessary for proper development of megakaryocytes and platelets and for bone marrow B lymphopoiesis[PMID: 21666133]. This protein is required for B-cell survival and proliferation in response to BCR stimulation, efficient IgG1 antibody responses to T-cell-dependent antigens and for normal induction of germinal center B cells. It may also be involved in neurogenesis and in the development of cortical architecture. MEF2C exists some isoforms with MV 50-52 kDa, 47 kDa, and 45 kDa, but modified MEF2C is about 55-66 kDa.
实验方案
| Product Specific Protocols | |
|---|---|
| IF protocol for MEF2C antibody 18290-1-AP | Download protocol |
| IHC protocol for MEF2C antibody 18290-1-AP | Download protocol |
| WB protocol for MEF2C antibody 18290-1-AP | Download protocol |
| Standard Protocols | |
|---|---|
| Click here to view our Standard Protocols |
发表文章
| Species | Application | Title |
|---|---|---|
Nature Genetic and epigenetic coordination of cortical interneuron development.
| ||
Biol Reprod Integrated microRNA and mRNA network analysis of the human myometrial transcriptome in the transition from quiescence to labor. | ||
Cell Rep Chromatin Environment and Cellular Context Specify Compensatory Activity of Paralogous MEF2 Transcription Factors. | ||
Cell Genom Single nucleus multiomics identifies ZEB1 and MAFB as candidate regulators of Alzheimer's disease-specific cis-regulatory elements | ||
Int J Mol Sci miR-1 as a Key Epigenetic Regulator in Early Differentiation of Cardiac Sinoatrial Region |